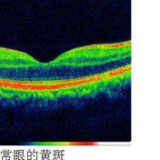

红网时刻新闻6月25日讯(通讯员 王娟 唐玥)袁叔叔今年65岁,在十几年前确诊糖尿病以来,饮食、生活习惯上都十分注意,血糖一直控制在正常的范围内,却没想到十几年后糖尿病史引发的并发症让他险些失明。
早在2020年7月,袁叔叔就发现自己的视力开始慢慢变差,看东西也逐渐模糊变形,后来眼睛上方有一块黑影挡住视线,同时眼前还看到好多“蚊子”在飞,意识到不对劲的袁叔叔在邻居的提醒下决定去颇有口碑的湘潭爱尔眼科医院看看。看诊当天袁叔叔看到有人送锦旗给胡栋院长,更加坚定了来湘潭爱尔眼科医院是正确的选择。
经医疗团队的初步检查,袁叔叔的双眼视力仅有0.15/0.04,完善眼底照相、OCT等更详细的检查后发现袁叔叔双眼黄斑区水肿,视网膜已存在大量出血点,诊断为“双眼糖尿病性视网膜病变”。黄斑水肿会对中心视力造成严重影响,若不及时采取措施,将会造成永久损害。

胡栋与袁叔叔详细地解释了他的病情,并建议他住院进行治疗。袁叔叔术前积极控制血糖、血压,一切准备就绪后很快为袁叔叔实施了“玻璃体腔内注药术”。术后恢复一段时间后,袁叔叔的术前症状逐渐好转,视力也有了提高。复查时,袁叔叔对后续的治疗也有了很大的信心:“刚开始吓到了,平常血糖控制都不错,没想到还是影响到眼睛了,差点失明,后续的治疗还是会选择湘潭爱尔眼科医院!”
胡栋提醒,糖尿病性黄斑水肿发生会造成严重的视力下降,主要表现在视野的中心区域会有暗点(也就是斑片状的视物模糊)、难以清晰地看到细节、看物体的形状有所改变、比实际形状变大或变小、直线在视野的某些部分出现波浪状或断裂等。
黄斑水肿要终身治疗,但这并不意味着患者的视力一定会走向失明的最坏结果。胡栋解释,如果患者能及早开始并坚持规范治疗,控制住水肿,视力就可以维持。要及时开始治疗,就要求患者能发现黄斑水肿的早期症状。目前常规的眼底检查手段可以及时发现眼底异常情况,所以早发现早治疗才是关键。
来源:红网
作者:王娟 唐玥
编辑:吕周阳
本站原创文章,转载请附上原文链接。
本文链接:https://health.rednet.cn/content/2022/06/25/11428630.html